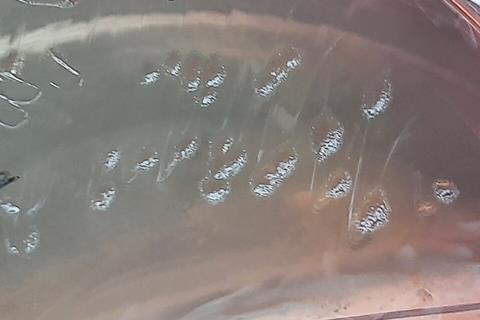
Pseudomonas_aeruginosa_colony_morphology_on_MacConkey_agar

Overuse of antibiotics has accelerated the development of bacterial resistance to conventional drugs, a global health crisis projected to result in more than 10 million deaths annually by 2050. The multidrug-resistant bacterium Pseudomonas aeruginosa accounts for approximately one-fifth of hospital-acquired pneumonia cases and is associated with severe illness and increased mortality.
Nitric oxide is a therapeutic gas that researchers at Massachusetts General Hospital, a founding member of the Mass General Brigham healthcare system, helped establish as a life-saving therapy for hundreds of thousands of newborns with congenital heart disease.
Nearly 30 years later, investigators from the same laboratory at Mass General Brigham report that high-dose inhaled nitric oxide (iNO) demonstrates potential antimicrobial activity in preclinical models and is safe and feasible in early human studies, supporting further clinical investigation. The findings are published in Science Translational Medicine.
“This study provides a translational foundation rather than a definitive clinical solution,” said first author Binglan Yu, PhD, of the Mass General Brigham Department of Anesthesia, Critical Care and Pain Medicine. “Our findings demonstrate strong preclinical antipseudomonal effects together with reassuring human safety data.”
“These results justify the careful design of phase 2 and phase 3 clinical trials to formally assess clinical efficacy,” added co-first author Bijan Safaee Fakhr, MD, also of the MGB Department of Anesthesia, Critical Care and Pain Medicine.
Dose-dependent killing
In the study, researchers first demonstrated dose-dependent killing of Pseudomonas aeruginosa using nitric oxide-releasing compounds in vitro. They then showed that pigs with experimental P. aeruginosa pneumonia treated with high-dose iNO (300 parts per million) exhibited reduced bacterial burden, along with improved oxygenation and other markers of lung infection, compared with untreated animals.
READ MORE: Metal-organic frameworks could someday deliver antibacterial nitric oxide
READ MORE: Beewolves protect symbiont microbes from toxic gas release
To assess feasibility and safety in humans, the investigators evaluated repeated high-dose iNO exposure in 10 healthy volunteers and two critically ill patients affected by multidrug-resistant bacterial infection. The treatment was well tolerated, with no serious safety concerns observed. A retrospective analysis of patients who received high-dose iNO in clinical settings, mostly during the COVID-19 pandemic, further supported the safety profile of this approach.
“These results suggest a promising strategy that could complement existing treatments,” said senior author Lorenzo Berra, MD, of the MGB Department of Anesthesia, Critical Care and Pain Medicine. “However, rigorous clinical trials are essential before this approach can be considered for routine clinical use.”
No comments yet